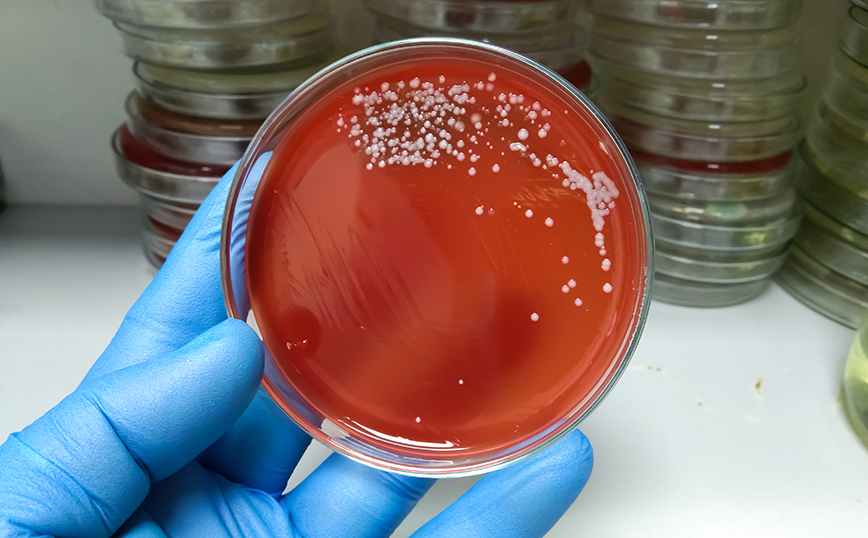
Στρεπτόκοκκος Στρεπτόκοκκος

Ιδιαίτερα κρίσιμη είναι η κατάσταση της υγείας της 40χρονης, η οποία νοσηλεύεται στη Μονάδα Εντατικής Θεραπείας του Γενικού Νοσοκομείου Λάρισας. Η γυναίκα έχει προσβληθεί από στρεπτόκοκκο.
Η 40χρονη πήγε χθες στο νοσοκομείο με συμπτώματα και λόγω της σοβαρότητας της κατάστασης της κρίθηκε απαραίτητη η εισαγωγή της στη ΜΕΘ, όπου δίνει μάχη για τη ζωή της με τους γιατρούς να χαρακτηρίζουν ιδιαίτερα κρίσιμο το 24ωρο που διανύουμε.
Σύμφωνα με τη δημοσιογράφος της ΕΡΤ Κωνσταντίνα Θεοχαρούλη, η κατάσταση της υγείας της 40χρονης σύμφωνα με τους θεράποντες γιατρούς χαρακτηρίζεται πάρα πολύ κρίσιμη. Η γυναίκα που μόλις πρόσφατα έφερε στον κόσμο το παιδί της διακομίσθηκε χθες στο Γενικό Νοσοκομείο Λάρισας με τα συμπτώματα της να έχουν προχωρήσει, ενώ ο οργανισμός της ήταν ιδιαίτερα καταβεβλημένος.
Η 40χρονη εισήχθη αμέσως και νοσηλεύεται στη Μονάδα Εντατικής Θεραπείας, όπου γιατροί καταβάλουν κάθε προσπάθεια προκειμένου να επανέλθει η γυναίκα και να μπορέσει να αποκατασταθεί όσο γίνεται η κατάσταση της υγείας της.
Μάλιστα προκειμένου να αντιμετωπιστούν τα πολλά προβλήματα που αντιμετωπίζει η γυναίκα μεταφέρθηκε χθες την νύχτα μηχάνημα από το Πανεπιστημιακό Νοσοκομείο της Λάρισας στο Γενικό Νοσοκομείο.
10 απαντήσεις από τον ΕΟΔΥ για τον στρεπτόκοκκο
1. Τι είναι ο στρεπτόκοκκος ομάδας Α;
Ο στρεπτόκοκκος της ομάδας Α, γνωστός και ως πυογόνος στρεπτόκοκκος ή GAS (Group A Streptococcus) είναι ένα βακτήριο που μπορεί να προκαλέσει διάφορες λοιμώξεις στον άνθρωπο, συνήθως ήπιες αλλά σε σπάνιες περιπτώσεις πολύ σοβαρές, ακόμη και θανατηφόρες αν δεν αντιμετωπιστούν κατάλληλα. Σε ένα μικρό ποσοστό (1-5%) ατόμων το βακτήριο εντοπίζεται στον φάρυγγα ή το δέρμα τους ή και σε άλλα σημεία, χωρίς να νοσούν, αποτελούν δηλαδή αυτά τα άτομα υγιείς φορείς του βακτηρίου
2. Πώς μεταδίδεται;
Ο στρεπτόκοκκος ομάδας Α μεταδίδεται μέσω:
- Των μολυσμένων σταγονιδίων από τις εκκρίσεις ασθενών
- Της επαφής με επιμολυσμένες επιφάνειες
- Την επαφή με μολυσμένες δερματικές βλάβες ασθενών
- Από υγιείς φορείς του βακτηρίου
Ο στρεπτόκοκκος ομάδας Α μεταδίδεται πολύ πιο εύκολα από άτομα που είναι συμπωματικά και νοσούν, παρά από υγιείς φορείς του βακτηρίου.
3. Πώς μπορεί να εκδηλωθεί μια λοίμωξη από τον στρεπτόκοκκο ομάδας Α;
Ο στρεπτόκοκκος ομάδας Α συνήθως προκαλεί λοιμώξεις όπως φαρυγγοαμυγδαλίτιδα (strep throat), πυρετό και δερματικό εξάνθημα γνωστό ως οστρακιά (scarlet fever), δερματικές λοιμώξεις όπως μολυσματικό κηρίο (impetigo) και κυτταρίτιδα (cellulitis), δηλαδή φλεγμονή της επιδερμίδας και του υποδόριου λίπους. Σε κάποιες περιπτώσεις εάν η στρεπτοκοκκική λοίμωξη δεν θεραπευτεί με τα κατάλληλα αντιβιοτικά μπορεί να οδηγήσει σε σοβαρές επιπλοκές όπως προσβολή των νεφρών (μεταστρεπτοκοκκική σπειραματονεφρίτιδα) ή της καρδιάς (ρευματικός πυρετός). Τα συμπτώματα που θα παρουσιάσει το πάσχον άτομο είναι ανάλογα με το είδος της λοίμωξης που θα του προκαλέσει το βακτήριο. Για παράδειγμα, η φαρυγγοαμυγδαλίτιδα εκδηλώνεται με πυρετό, κυνάγχη (πονόλαιμο), δυσκαταποσία, διόγκωση των αμυγδαλών με λευκωπό επίχρισμα, διόγκωση των λεμφαδένων και αιμορραγικά στίγματα (πετέχειες) στην υπερώα. Σε σπάνιες περιπτώσεις ο στρεπτόκοκκος ομάδας Α μπορεί να προκαλέσει διεισδυτική νόσο στον άνθρωπο (iGAS-invasive Group A Streptococcus), δηλαδή πολύ σοβαρή λοίμωξη που χωρίς την κατάλληλη και άμεση αντιμετώπιση μπορεί να οδηγήσει στον θάνατο. Μορφές διεισδυτικής νόσου του βακτηριδίου αποτελούν η νεκρωτική περιτονίτιδα (necrotizing fasciitis) και το στρεπτοκοκκικό σύνδρομο τοξικής καταπληξίας (Streptococcal Toxic Shock Syndrome).
4. Ποιοι είναι πιο ευάλωτοι για να νοσήσουν;
Οποιοσδήποτε μπορεί να νοσήσει από στρεπτοκοκκική λοίμωξη. Ωστόσο πιο ευάλωτοι στο βακτήριο είναι τα μικρά παιδιά, οι ηλικιωμένοι, οι ανοσοκατεσταλμένοι, οι άνθρωποι με χρόνια νοσήματα και όσοι διαβιούν σε κακές συνθήκες υγιεινής και σε συνθήκες συγχρωτισμού. Ο πυογόνος στρεπτόκοκκος αποτελεί ένα από τα πιο συχνά αίτια φαρυγγοαμυγδαλίτιδας στα παιδιά σχολικής ηλικίας.
5. Υπάρχει εμβόλιο για τον στρεπτόκοκκο της ομάδας Α;
Αυτή τη στιγμή δεν υπάρχει εμβόλιο για την πρόληψη της στρεπτοκοκκικής λοίμωξης από τον πυογόνο στρεπτόκοκκο ομάδας Α. Ωστόσο, υπάρχουν κάποια εμβόλια υπό μελέτη εναντί του βακτηρίου.
6. Ποια είναι τα μέτρα πρόληψης της λοίμωξης;
Τα μέτρα πρόληψης της στρεπτοκοκκικής λοίμωξης από τον πυογόνο στρεπτόκοκκο περιλαμβάνουν:
- Σωστή εφαρμογή των κανόνων υγιεινής και της υγιεινής των χεριών
- Εφαρμογή των μέτρων ατομικής προστασίας
- Αποφυγή του συγχρωτισμού και σωστό αερισμό των χώρων
- Σωστή καθαριότητα και απολύμανση των επιφανειών και των συχνά χρησιμοποιούμενων αντικειμένων, σύμφωνα με τις οδηγίες των ειδικών
- Περιορισμός των ατόμων που νοσούν σε κατ’ οίκον νοσηλεία, τουλάχιστον για ένα εικοσιτετράωρο μετά την έναρξη της αντιβιοτικής τους αγωγής
7. Πώς μπορεί να διαγνωσθεί μια λοίμωξη στρεπτόκοκκου ομάδας Α;
Υπάρχουν διάφορες εξετάσεις για τη διάγνωση της λοίμωξης από τον στρεπτόκοκκο ομάδας Α ανάλογα με την κλινική εικόνα του ασθενούς. Για παράδειγμα, η στρεπτοκοκκική φαρυγγοαμυγδαλίτιδα μπορεί γρήγορα να διαγνωσθεί με καλλιέργεια φαρυγγικού επιχρίσματος καθώς επίσης και με ένα ταχύ τεστ ανίχνευσης του αντιγόνου του στρεπτοκόκκου, γνωστό ως step test.
8. Ποια είναι η θεραπεία;
Η στρεπτοκοκκική λοίμωξη από τον στρεπτόκοκκο ομάδας Α πρέπει εγκαίρως να αντιμετωπίζεται με τα κατάλληλα αντιβιοτικά, ανάλογα με τη βαρύτητα της λοίμωξης.
9. Πότε θα πρέπει να αναζητήσω βοήθεια;
Ο πυρετός που επιμένει, η έντονη κυνάγχη, η δυσκαταποσία, ο πυρετός σε συνδυασμό με εξάνθημα, η έντονη καταβολή είναι συμπτώματα που πρέπει να αναζητήσουμε άμεσα ιατρική βοήθεια. Η διεισδυτική λοίμωξη από τον πυογόνο στρεπτόκοκκο εξελίσσεται ταχύτατα γι’ αυτό οποιαδήποτε υποψία νόσου χρήζει άμεσης ιατρικής εκτίμησης.
10. Η διεισδυτική λοίμωξη από τον στρεπτόκοκκο ομάδας Α επιτηρείται στην Ελλάδα;
H διεισδυτική λοίμωξη από τον στρεπτόκοκκο ομάδας Α δεν επιτηρείται στην Ελλάδα, όπως επιτηρείται σε κάποιες άλλες χώρες, όπως η Γαλλία, η Ισπανία και η Αγγλία. Τους τελευταίους μήνες αναφέρεται μία αύξηση στα συγκεκριμένα περιστατικά (iGAS) σε κάποιες χώρες σε παιδιά ηλικίας κάτω των δέκα ετών, ενώ αναφέρονται και θανατηφόρα κρούσματα. Το ECDC, ο WHO και το CDC παρακολουθούν στενά τα επιδημιολογικά δεδομένα και συστήνουν επαγρύπνηση τόσο των αρμοδίων φορέων όσο και του κοινού για αναζήτηση άμεσης ιατρικής φροντίδας σε περίπτωση ύποπτων συμπτωμάτων. Σύμφωνα με το ECDC πιθανολογείται ότι η αύξηση των κρουσμάτων διεισδυτικής νόσου από τον στρεπτόκοκκο ομάδας Α συσχετίζεται με την πρόσφατη αύξηση της κυκλοφορίας πολλών αναπνευστικών ιών, όπως ο ιός της γρίπης και ο RSV ιός, καθώς η συλλοίμωξη ιών με τον στρεπτόκοκκο ομάδας Α, ευνοεί την εκδήλωση διεισδυτικής νόσου. Για το λόγο αυτό η εφαρμογή των προαναφερθέντων μέτρων πρόληψης αποτελούν την καλύτερη ασπίδα στην πρόληψη των λοιμωδών νοσημάτων.
























































